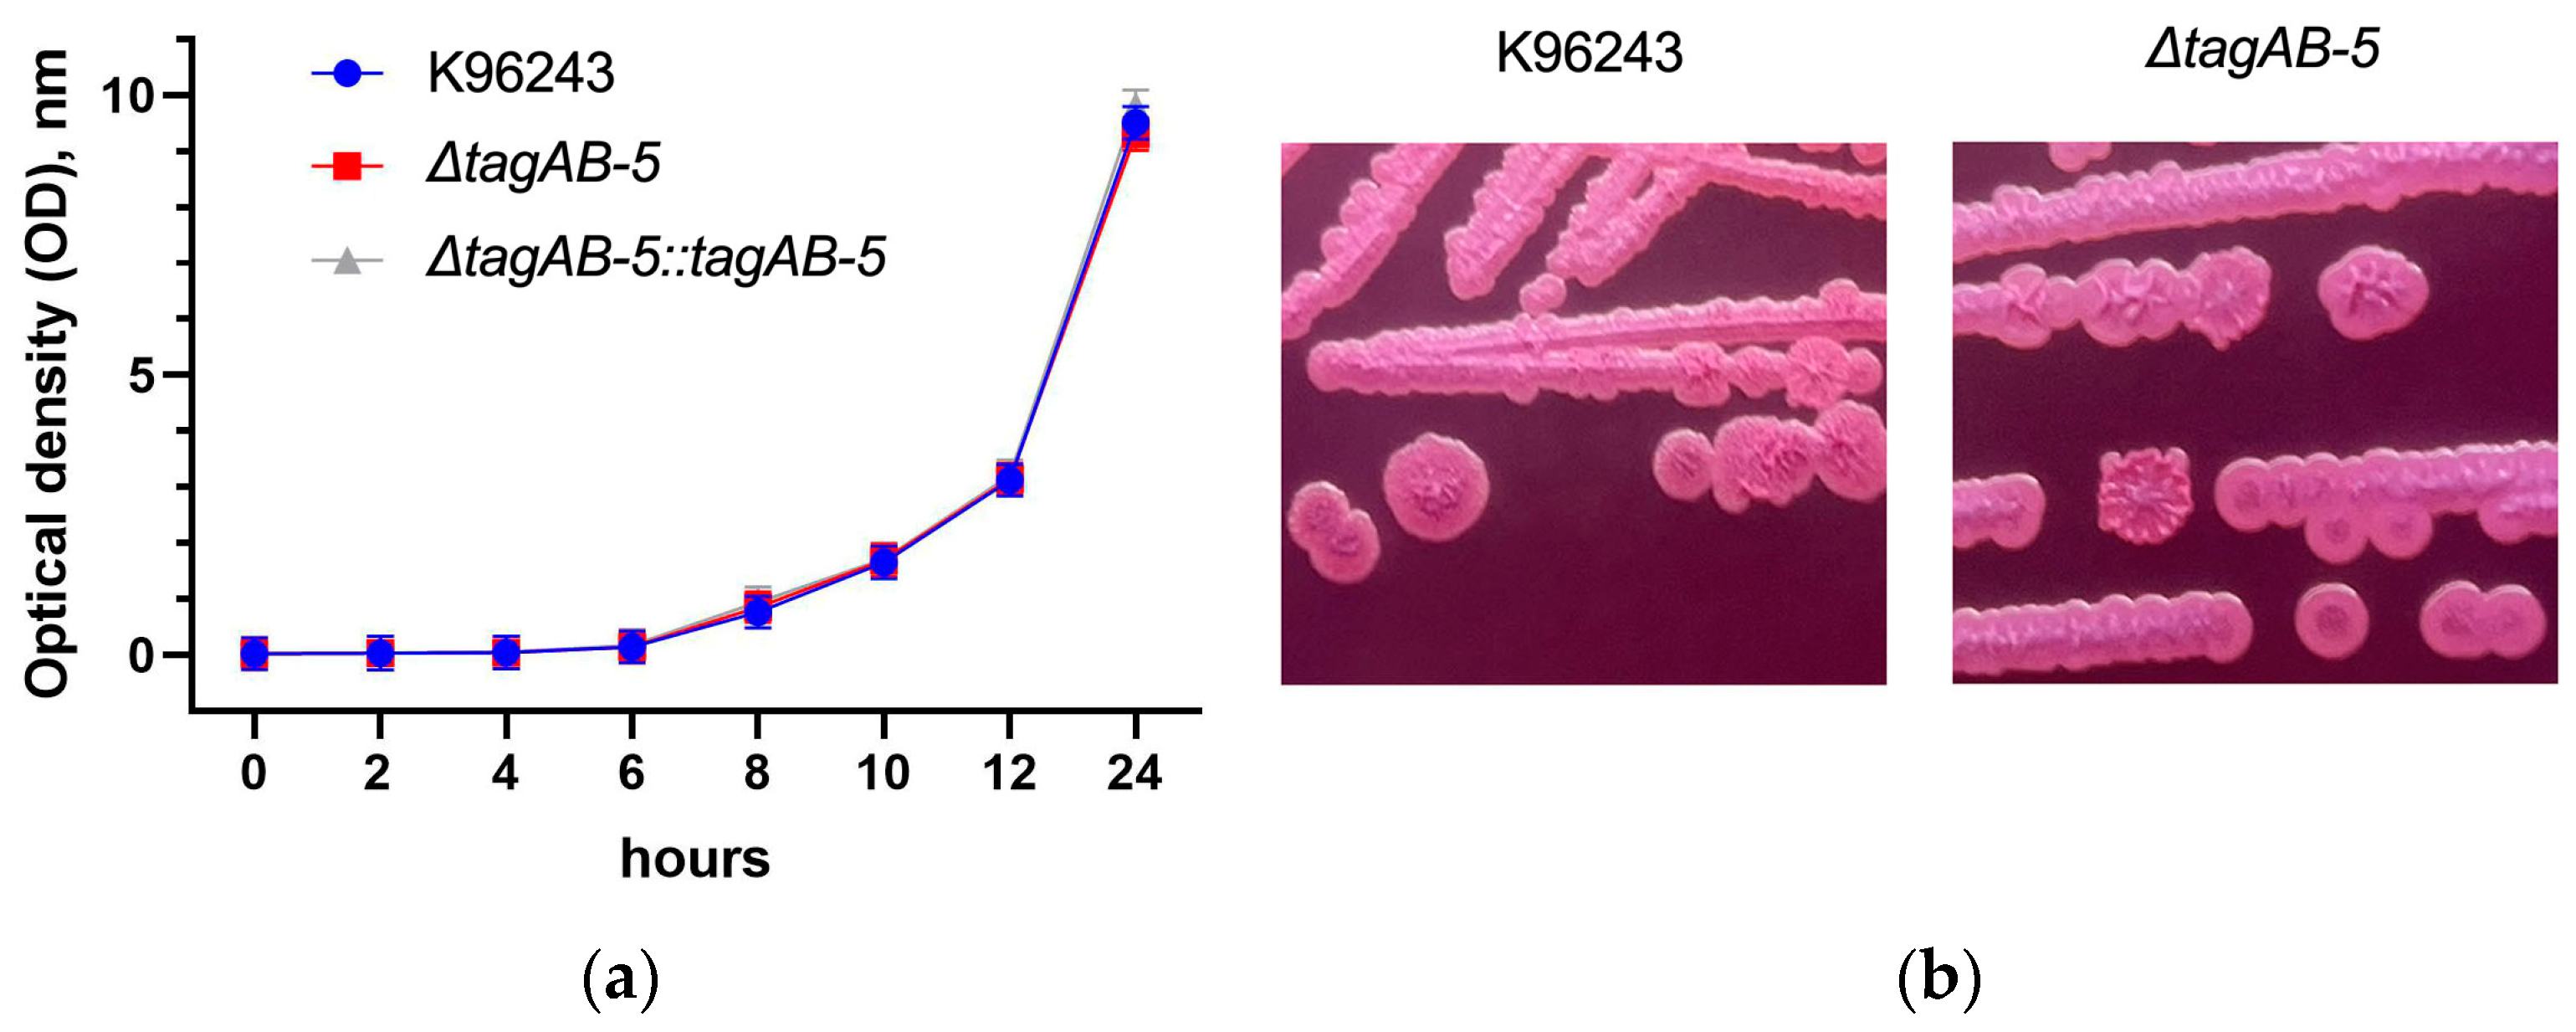
Biomedicines 11 02927 g001

Type VI Secretion System Accessory Protein TagAB-5 Promotes Burkholderia pseudomallei Pathogenicity in Human Microglia
Abstract
:1. Introduction
2. Materials and Methods
2.1. Biosecurity Aspects
2.2. Bacterial Strains, Cell Line, and Growth Conditions
2.3. Construction of B. pseudomallei tagAB-5 Deletion Mutant and Complementary Strains
2.4. Growth Assay
2.5. Internalization and Intracellular Replication Assay
2.6. Multinucleated Giant Cell (MNGC) Formation Assay
2.7. Actin Tail Formation Assay
2.8. Lactate Dehydrogenase (LDH) Detection
2.9. Cytokine Expression
2.10. Antimicrobial Susceptibility Testing
2.11. Galleria mellonella Killing Assay
2.12. Statistical Analysis
3. Results
3.1. Effect of TagAB-5 Deletion on B. pseudomallei Growth, Colony Morphology, and Antimicrobial Susceptibility
3.2. TagAB-5 Plays Role in Intracellular Survival of Human Microglia Cells
3.3. TagAB-5 Is Required for Multinucleated Giant Cell (MNGC) Formation
3.4. TagAB-5 Effects on Damage in B. pseudomallei-Infected HCM3 Cells
3.5. TagAB-5 Strengthens the Inflammatory Response of HMC3 Cells
3.6. Role of TagAB-5 in B. pseudomallei Virulence in an In Vivo Model
4. Discussion
5. Conclusions
Supplementary Materials
Author Contributions
Funding
Institutional Review Board Statement
Informed Consent Statement
Data Availability Statement
Acknowledgments
Conflicts of Interest
References
- Hinjoy, S.; Hantrakun, V.; Kongyu, S.; Kaewrakmuk, J.; Wangrangsimakul, T.; Jitsuronk, S.; Saengchun, W.; Bhengsri, S.; Akarachotpong, T.; Thamthitiwat, S.; et al. Melioidosis in Thailand: Present and Future. Trop. Med. Infect. Dis. 2018, 3, 38. [Google Scholar] [CrossRef]
- Hantrakun, V.; Kongyu, S.; Klaytong, P.; Rongsumlee, S.; Day, N.P.J.; Peacock, S.J.; Hinjoy, S.; Limmathurotsakul, D. Clinical Epidemiology of 7126 Melioidosis Patients in Thailand and the Implications for a National Notifiable Diseases Surveillance System. Open Forum Infect. Dis. 2019, 6, ofz498. [Google Scholar] [CrossRef]
- Cossaboom, C.M.; Marinova-Petkova, A.; Strysko, J.; Rodriguez, G.; Maness, T.; Ocampo, J.; Gee, J.E.; Elrod, M.G.; Gulvik, C.A.; Liu, L.; et al. Melioidosis in a Resident of Texas with No Recent Travel History, United States. Emerg. Infect. Dis. 2020, 26, 1295–1299. [Google Scholar] [CrossRef]
- Arya, A.; Shaikh, H.; Weber, D.; Pettengill, M.; Moss, S. Fever in a returning traveler: A case and literature review of melioidosis. IDCases 2021, 26, e01340. [Google Scholar] [CrossRef]
- Currie, B.J.; Ward, L.; Cheng, A.C. The Epidemiology and Clinical Spectrum of Melioidosis: 540 Cases from the 20 Year Darwin Prospective Study. PLoS Neglected Trop. Dis. 2010, 4, e900. [Google Scholar] [CrossRef]
- Limmathurotsakul, D.; Chaowagul, W.; Wongsrikaew, P.; Narmwong, A.; Day, N.P.; Peacock, S.J. Variable Presentation of Neurological Melioidosis in Northeast Thailand. Am. J. Trop. Med. Hyg. 2007, 77, 118–120. [Google Scholar] [CrossRef]
- Deuble, M.; Aquilina, C.; Norton, R. Neurologic melioidosis. Am. J. Trop. Med. Hyg. 2013, 89, 535–539. [Google Scholar] [CrossRef]
- Wongwandee, M.; Linasmita, P. Central nervous system melioidosis: A systematic review of individual participant data of case reports and case series. PLoS Neglected Trop. Dis. 2019, 13, e0007320. [Google Scholar] [CrossRef]
- John, J.A.S.; Ekberg Jenny, A.K.; Dando Samantha, J.; Meedeniya Adrian, C.B.; Horton Rachel, E.; Batzloff, M.; Owen Suzzanne, J.; Holt, S.; Peak Ian, R.; Ulett Glen, C.; et al. Burkholderia pseudomallei Penetrates the Brain via Destruction of the Olfactory and Trigeminal Nerves: Implications for the Pathogenesis of Neurological Melioidosis. Mbio 2014, 5, e00025-14. [Google Scholar] [CrossRef]
- John, J.A.S.; Walkden, H.; Nazareth, L.; Beagley Kenneth, W.; Ulett Glen, C.; Batzloff Michael, R.; Beacham Ifor, R.; Ekberg Jenny, A.K.; Palmer, G.H. Burkholderia pseudomallei Rapidly Infects the Brain Stem and Spinal Cord via the Trigeminal Nerve after Intranasal Inoculation. Infect. Immun. 2016, 84, 2681–2688. [Google Scholar] [CrossRef]
- Huang, W.-Y.; Wu, G.; Chen, F.; Li, M.-M.; Li, J.-J. Multi-systemic melioidosis: A clinical, neurological, and radiological case study from Hainan Province, China. BMC Infect. Dis. 2018, 18, 649. [Google Scholar] [CrossRef]
- Chen, Y.S.; Lin, H.H.; Hsueh, P.T.; Ni, W.F.; Liu, P.J.; Chen, P.S.; Chang, H.H.; Sun, D.S.; Chen, Y.L. Involvement of L-selectin expression in Burkholderia pseudomallei-infected monocytes invading the brain during murine melioidosis. Virulence 2017, 8, 751–766. [Google Scholar] [CrossRef]
- Liu, P.J.; Chen, Y.S.; Lin, H.H.; Ni, W.F.; Hsieh, T.H.; Chen, H.T.; Chen, Y.L. Induction of mouse melioidosis with meningitis by CD11b+ phagocytic cells harboring intracellular B. pseudomallei as a Trojan horse. PLoS Negl. Trop. Dis. 2013, 7, e2363. [Google Scholar] [CrossRef]
- Donnelly, C.R.; Andriessen, A.S.; Chen, G.; Wang, K.; Jiang, C.; Maixner, W.; Ji, R.R. Central Nervous System Targets: Glial Cell Mechanisms in Chronic Pain. Neurotherapeutics 2020, 17, 846–860. [Google Scholar] [CrossRef]
- Stoll, G.; Jander, S. Microglia. In Reference Module in Neuroscience and Biobehavioral Psychology; Elsevier: Amsterdam, The Netherlands, 2017. [Google Scholar] [CrossRef]
- Rungruengkitkun, A.; Jitprasutwit, N.; Muangkaew, W.; Suttikornchai, C.; Tandhavanant, S.; Indrawattana, N.; Ampawong, S.; Sukphopetch, P.; Chantratita, N.; Pumirat, P. Cycle-Inhibiting Factor Is Associated with Burkholderia pseudomallei Invasion in Human Neuronal Cells. Biology 2022, 11, 1439. [Google Scholar] [CrossRef]
- Jitprasutwit, N.; Rungruengkitkun, A.; Lohitthai, S.; Reamtong, O.; Indrawattana, N.; Sookrung, N.; Sricharunrat, T.; Sukphopetch, P.; Chatratita, N.; Pumirat, P. In Vitro Roles of Burkholderia Intracellular Motility A (BimA) in Infection of Human Neuroblastoma Cell Line. Microbiol. Spectr. 2023, 11, e0132023. [Google Scholar] [CrossRef]
- Neumann, H.; Kotter, M.R.; Franklin, R.J. Debris clearance by microglia: An essential link between degeneration and regeneration. Brain 2009, 132, 288–295. [Google Scholar] [CrossRef]
- Smith, J.A.; Das, A.; Ray, S.K.; Banik, N.L. Role of pro-inflammatory cytokines released from microglia in neurodegenerative diseases. Brain Res. Bull. 2012, 87, 10–20. [Google Scholar] [CrossRef]
- Hsueh, P.-T.; Lin, H.-H.; Liu, C.-L.; Ni, W.-F.; Chen, Y.-L.; Chen, Y.-S. Burkholderia pseudomallei-loaded cells act as a Trojan horse to invade the brain during endotoxemia. Sci. Rep. 2018, 8, 13632. [Google Scholar] [CrossRef]
- Hopf, V.; Göhler, A.; Eske-Pogodda, K.; Bast, A.; Steinmetz, I.; Breitbach, K. BPSS1504, a cluster 1 type VI secretion gene, is involved in intracellular survival and virulence of Burkholderia pseudomallei. Infect. Immun. 2014, 82, 2006–2015. [Google Scholar] [CrossRef]
- Burtnick, M.N.; Brett, P.J.; Harding, S.V.; Ngugi, S.A.; Ribot, W.J.; Chantratita, N.; Scorpio, A.; Milne, T.S.; Dean, R.E.; Fritz, D.L.; et al. The cluster 1 type VI secretion system is a major virulence determinant in Burkholderia pseudomallei. Infect. Immun. 2011, 79, 1512–1525. [Google Scholar] [CrossRef]
- Lennings, J.; West, T.E.; Schwarz, S. The Burkholderia Type VI Secretion System 5: Composition, Regulation and Role in Virulence. Front. Microbiol. 2019, 9, 3339. [Google Scholar] [CrossRef]
- Browne, N.; Kavanagh, K. Developing the potential of using Galleria mellonella larvae as models for studying brain infection by Listeria monocytogenes. Virulence 2013, 4, 271–272. [Google Scholar] [CrossRef]
- Pumirat, P.; Boonyuen, U.; Vanaporn, M.; Pinweha, P.; Tandhavanant, S.; Korbsrisate, S.; Chantratita, N. The role of short-chain dehydrogenase/oxidoreductase, induced by salt stress, on host interaction of B. pseudomallei. BMC Microbiol. 2014, 14, 1. [Google Scholar] [CrossRef]
- López, C.M.; Rholl, D.A.; Trunck, L.A.; Schweizer, H.P. Versatile dual-technology system for markerless allele replacement in Burkholderia pseudomallei. Appl. Environ. Microbiol. 2009, 75, 6496–6503. [Google Scholar] [CrossRef]
- Chantratita, N.; Wuthiekanun, V.; Boonbumrung, K.; Tiyawisutsri, R.; Vesaratchavest, M.; Limmathurotsakul, D.; Chierakul, W.; Wongratanacheewin, S.; Pukritiyakamee, S.; White, N.J.; et al. Biological relevance of colony morphology and phenotypic switching by Burkholderia pseudomallei. J. Bacteriol. 2007, 189, 807–817. [Google Scholar] [CrossRef]
- Monod, J. The growth of bacterial cultures. Ann. Rev. Microbiol. 1949, 3, 371–394. [Google Scholar] [CrossRef]
- Dance, D.A.B.; Wuthiekanun, V.; Baird, R.W.; Norton, R.; Limmathurotsakul, D.; Currie, B.J. Interpreting Burkholderia pseudomallei disc diffusion susceptibility test results by the EUCAST method. Clin. Microbiol. Infect. 2021, 27, 827–829. [Google Scholar] [CrossRef]
- Duangurai, T.; Reamtong, O.; Rungruengkitkun, A.; Srinon, V.; Boonyuen, U.; Limmathurotsakul, D.; Chantratita, N.; Pumirat, P. In vitro passage alters virulence, immune activation and proteomic profiles of Burkholderia pseudomallei. Sci. Rep. 2020, 10, 8320. [Google Scholar] [CrossRef]
- Chan, F.K.; Moriwaki, K.; De Rosa, M.J. Detection of necrosis by release of lactate dehydrogenase activity. Methods Mol. Biol. 2013, 979, 65–70. [Google Scholar] [CrossRef]
- Owen, W.; Smith, S.; Kuruvath, S.; Anderson, D.; Hanson, J. Melioidosis of the central nervous system; A potentially lethal impersonator. IDCases 2021, 23, e01015. [Google Scholar] [CrossRef]
- Walkden, H.; Delbaz, A.; Nazareth, L.; Batzloff, M.; Shelper, T.; Beacham, I.R.; Chacko, A.; Shah, M.; Beagley, K.W.; Tello Velasquez, J.; et al. Burkholderia pseudomallei invades the olfactory nerve and bulb after epithelial injury in mice and causes the formation of multinucleated giant glial cells in vitro. PLoS Negl. Trop. Dis. 2020, 14, e0008017. [Google Scholar] [CrossRef]
- Colonna, M.; Butovsky, O. Microglia Function in the Central Nervous System During Health and Neurodegeneration. Annu. Rev. Immunol. 2017, 35, 441–468. [Google Scholar] [CrossRef]
- Thorsdottir, S.; Henriques-Normark, B.; Iovino, F. The Role of Microglia in Bacterial Meningitis: Inflammatory Response, Experimental Models and New Neuroprotective Therapeutic Strategies. Front. Microbiol. 2019, 10, 576. [Google Scholar] [CrossRef]
- Cascales, E.; Cambillau, C. Structural biology of type VI secretion systems. Philos. Trans. R. Soc. Lond. B Biol. Sci. 2012, 367, 1102–1111. [Google Scholar] [CrossRef]
- Morgado, S.; Vicente, A.C. Diversity and distribution of Type VI Secretion System gene clusters in bacterial plasmids. Sci. Rep. 2022, 12, 8249. [Google Scholar] [CrossRef]
- Shalom, G.; Shaw, J.G.; Thomas, M.S. In vivo expression technology identifies a type VI secretion system locus in Burkholderia pseudomallei that is induced upon invasion of macrophages. Microbiology 2007, 153, 2689–2699. [Google Scholar] [CrossRef] [PubMed]
- Kovacs-Simon, A.; Hemsley, C.M.; Scott, A.E.; Prior, J.L.; Titball, R.W. Burkholderia thailandensis strain E555 is a surrogate for the investigation of Burkholderia pseudomallei replication and survival in macrophages. BMC Microbiol. 2019, 19, 97. [Google Scholar] [CrossRef]
- Wang, Q.; Boshoff, H.I.M.; Harrison, J.R.; Ray, P.C.; Green, S.R.; Wyatt, P.G.; Barry, C.E., 3rd. PE/PPE proteins mediate nutrient transport across the outer membrane of Mycobacterium tuberculosis. Science 2020, 367, 1147–1151. [Google Scholar] [CrossRef]
- Di Luca, M.; Bottai, D.; Batoni, G.; Orgeur, M.; Aulicino, A.; Counoupas, C.; Campa, M.; Brosch, R.; Esin, S. The ESX-5 associated eccB-EccC locus is essential for Mycobacterium tuberculosis viability. PLoS ONE 2012, 7, e52059. [Google Scholar] [CrossRef]
- Bottai, D.; Di Luca, M.; Majlessi, L.; Frigui, W.; Simeone, R.; Sayes, F.; Bitter, W.; Brennan, M.J.; Leclerc, C.; Batoni, G.; et al. Disruption of the ESX-5 system of Mycobacterium tuberculosis causes loss of PPE protein secretion, reduction of cell wall integrity and strong attenuation. Mol. Microbiol. 2012, 83, 1195–1209. [Google Scholar] [CrossRef] [PubMed]
- Wikraiphat, C.; Saiprom, N.; Tandhavanant, S.; Heiss, C.; Azadi, P.; Wongsuvan, G.; Tuanyok, A.; Holden, M.T.; Burtnick, M.N.; Brett, P.J.; et al. Colony morphology variation of Burkholderia pseudomallei is associated with antigenic variation and O-polysaccharide modification. Infect. Immun. 2015, 83, 2127–2138. [Google Scholar] [CrossRef]
- Wang, J.; Zhou, Z.; He, F.; Ruan, Z.; Jiang, Y.; Hua, X.; Yu, Y. The role of the type VI secretion system vgrG gene in the virulence and antimicrobial resistance of Acinetobacter baumannii ATCC 19606. PLoS ONE 2018, 13, e0192288. [Google Scholar] [CrossRef] [PubMed]
- Wang, P.; Dong, J.F.; Li, R.Q.; Li, L.; Zou, Q.H. Roles of the Hcp family proteins in the pathogenicity of Salmonella typhimurium 14028s. Virulence 2020, 11, 1716–1726. [Google Scholar] [CrossRef] [PubMed]
- Shrivastava, S.; Mande, S.S. Identification and functional characterization of gene components of Type VI Secretion system in bacterial genomes. PLoS ONE 2008, 3, e2955. [Google Scholar] [CrossRef] [PubMed]
- Lin, L.; Capozzoli, R.; Ferrand, A.; Plum, M.; Vettiger, A.; Basler, M. Subcellular localization of Type VI secretion system assembly in response to cell-cell contact. EMBO J. 2022, 41, e108595. [Google Scholar] [CrossRef] [PubMed]
- Kang, W.-T.; Vellasamy, K.M.; Chua, E.-G.; Vadivelu, J. Functional characterizations of effector protein BipC, a type III secretion system protein, in Burkholderia pseudomallei pathogenesis. J. Infect. Dis. 2015, 211, 827–834. [Google Scholar] [CrossRef]
- Stevens, M.P.; Friebel, A.; Taylor, L.A.; Wood, M.W.; Brown, P.J.; Hardt, W.D.; Galyov, E.E. A Burkholderia pseudomallei type III secreted protein, BopE, facilitates bacterial invasion of epithelial cells and exhibits guanine nucleotide exchange factor activity. J. Bacteriol. 2003, 185, 4992–4996. [Google Scholar] [CrossRef]
- Kaewpan, A.; Duangurai, T.; Rungruengkitkun, A.; Muangkaew, W.; Kanjanapruthipong, T.; Jitprasutwit, N.; Ampawong, S.; Sukphopetch, P.; Chantratita, N.; Pumirat, P. Burkholderia pseudomallei pathogenesis in human skin fibroblasts: A Bsa type III secretion system is involved in the invasion, multinucleated giant cell formation, and cellular damage. PLoS ONE 2022, 17, e0261961. [Google Scholar] [CrossRef]
- Lamason, R.L.; Welch, M.D. Actin-based motility and cell-to-cell spread of bacterial pathogens. Curr. Opin. Microbiol. 2017, 35, 48–57. [Google Scholar] [CrossRef]
- Kespichayawattana, W.; Rattanachetkul, S.; Wanun, T.; Utaisincharoen, P.; Sirisinha, S. Burkholderia pseudomallei induces cell fusion and actin-associated membrane protrusion: A possible mechanism for cell-to-cell spreading. Infect. Immun. 2000, 68, 5377–5384. [Google Scholar] [CrossRef]
- Mariappan, V.; Vellasamy, K.M.; Barathan, M.; Girija, A.S.S.; Shankar, E.M.; Vadivelu, J. Hijacking of the Host’s Immune Surveillance Radars by Burkholderia pseudomallei. Front. Immunol. 2021, 12, 718719. [Google Scholar] [CrossRef] [PubMed]
- Burtnick, M.N.; DeShazer, D.; Nair, V.; Gherardini, F.C.; Brett, P.J. Burkholderia mallei cluster 1 type VI secretion mutants exhibit growth and actin polymerization defects in RAW 264.7 murine macrophages. Infect. Immun. 2010, 78, 88–99. [Google Scholar] [CrossRef]
- Tambuyzer, B.R.; Ponsaerts, P.; Nouwen, E.J. Microglia: Gatekeepers of central nervous system immunology. J. Leukoc. Biol. 2009, 85, 352–370. [Google Scholar] [CrossRef]
- Alcoforado Diniz, J.; Liu, Y.C.; Coulthurst, S.J. Molecular weaponry: Diverse effectors delivered by the Type VI secretion system. Cell Microbiol. 2015, 17, 1742–1751. [Google Scholar] [CrossRef]
- Rodríguez, A.M.; Rodríguez, J.; Giambartolomei, G.H. Microglia at the Crossroads of Pathogen-Induced Neuroinflammation. ASN Neuro 2022, 14, 17590914221104566. [Google Scholar] [CrossRef] [PubMed]
- van Furth, A.M.; Roord, J.J.; van Furth, R. Roles of proinflammatory and anti-inflammatory cytokines in pathophysiology of bacterial meningitis and effect of adjunctive therapy. Infect. Immun. 1996, 64, 4883–4890. [Google Scholar] [CrossRef]
- Ehrlich, L.C.; Hu, S.; Sheng, W.S.; Sutton, R.L.; Rockswold, G.L.; Peterson, P.K.; Chao, C.C. Cytokine Regulation of Human Microglial Cell IL-8 Production1. J. Immunol. 1998, 160, 1944–1948. [Google Scholar] [CrossRef]
- Kunyanee, C.; Kamjumphol, W.; Taweechaisupapong, S.; Kanthawong, S.; Wongwajana, S.; Wongratanacheewin, S.; Hahnvajanawong, C.; Chareonsudjai, S. Burkholderia pseudomallei Biofilm Promotes Adhesion, Internalization and Stimulates Proinflammatory Cytokines in Human Epithelial A549 Cells. PLoS ONE 2016, 11, e0160741. [Google Scholar] [CrossRef]
- Mattrasongkram, P.; Wongkaewkhiaw, S.; Taweechaisupapong, S.; Chareonsudjai, S.; Techawiwattanaboon, T.; Ngamsiri, T.; Kanthawong, S. Vitamin D (1α,25(OH)2D3) supplementation minimized multinucleated giant cells formation and inflammatory response during Burkholderia pseudomallei infection in human lung epithelial cells. PLoS ONE 2023, 18, e0280944. [Google Scholar] [CrossRef] [PubMed]
- Lee, T.T.; Martin, F.C.; Merrill, J.E. Lymphokine induction of rat microglia multinucleated giant cell formation. Glia 1993, 8, 51–61. [Google Scholar] [CrossRef]
- Suputtamongkol, Y.; Kwiatkowski, D.; Dance, D.A.; Chaowagul, W.; White, N.J. Tumor necrosis factor in septicemic melioidosis. J. Infect. Dis. 1992, 165, 561–564. [Google Scholar] [CrossRef]
- Ulett, G.C.; Ketheesan, N.; Hirst, R.G. Proinflammatory cytokine mRNA responses in experimental Burkholderia pseudomallei infection in mice. Acta Trop. 2000, 74, 229–234. [Google Scholar] [CrossRef] [PubMed]
- Kavanagh, K.; Reeves, E.P. Exploiting the potential of insects for in vivo pathogenicity testing of microbial pathogens. FEMS Microbiol. Rev. 2004, 28, 101–112. [Google Scholar] [CrossRef] [PubMed]
- Wand, M.E.; Müller, C.M.; Titball, R.W.; Michell, S.L. Macrophage and Galleria mellonella infection models reflect the virulence of naturally occurring isolates of B. pseudomallei, B. thailandensis and B. oklahomensis. BMC Microbiol. 2011, 11, 11. [Google Scholar] [CrossRef] [PubMed]

| Bacterial Strains | Description | Source |
|---|---|---|
| K96243 | B. pseudomallei clinical strain | [25] |
| ΔtagAB-5 | K96243 tagAB-5 deletion mutant | This study |
| ΔtagAB-5::tagAB-5 | K96243 tagAB-5 complement strain | This study |
| Primer Names | Sequence (5′–3′) | Purpose | Size | Source |
|---|---|---|---|---|
| F1-BPSS1504 | 5′-gcgaagcccggggAGCTGAAGGCCAAGCAGA-3′ | Amplification of full-length tagAB-5 | 3431 | This study |
| R2-BPSS1504 | 5′-agcgtccccgggGCGAGGTCGGTTTCCGT-3′ | |||
| Seq-F-BPSS1504 | 5′-CGATGAGCGTCGGCAAGG-3′ | Amplification of flanking regions of tagAB-5 | 3566 | This study |
| Seq-R-BPSS1504 | 5′-CGGCTGAAATGGGTCATCGT-3′ | |||
| OriT-F | 5′-TCCGCTCATAACCCTGCTTC-3′ | Validation of the presence of pEXKm5 plasmid backbone | 236 | [16] |
| OriT-R | 5′-CAGCCTCGCAGAGCAGGATTC-3′ |
| Strains | AMC | CAZ | IMP | MEM | SXT | TE | C |
|---|---|---|---|---|---|---|---|
| K96243 | I | I | S | S | I | S | S |
| ΔtagAB-5 | I | I | S | S | I | S | S |
| ΔtagAB-5::tagAB-5 | I | I | S | S | I | S | S |
Disclaimer/Publisher’s Note: The statements, opinions and data contained in all publications are solely those of the individual author(s) and contributor(s) and not of MDPI and/or the editor(s). MDPI and/or the editor(s) disclaim responsibility for any injury to people or property resulting from any ideas, methods, instructions or products referred to in the content. |
© 2023 by the authors. Licensee MDPI, Basel, Switzerland. This article is an open access article distributed under the terms and conditions of the Creative Commons Attribution (CC BY) license (https://creativecommons.org/licenses/by/4.0/).
Share and Cite
Lohitthai, S.; Rungruengkitkun, A.; Jitprasutwit, N.; Kong-Ngoen, T.; Duangurai, T.; Tandhavanant, S.; Sukphopetch, P.; Chantratita, N.; Indrawattana, N.; Pumirat, P. Type VI Secretion System Accessory Protein TagAB-5 Promotes Burkholderia pseudomallei Pathogenicity in Human Microglia. Biomedicines 2023, 11, 2927. https://doi.org/10.3390/biomedicines11112927
Lohitthai S, Rungruengkitkun A, Jitprasutwit N, Kong-Ngoen T, Duangurai T, Tandhavanant S, Sukphopetch P, Chantratita N, Indrawattana N, Pumirat P. Type VI Secretion System Accessory Protein TagAB-5 Promotes Burkholderia pseudomallei Pathogenicity in Human Microglia. Biomedicines. 2023; 11(11):2927. https://doi.org/10.3390/biomedicines11112927
Chicago/Turabian StyleLohitthai, Sanisa, Amporn Rungruengkitkun, Niramol Jitprasutwit, Thida Kong-Ngoen, Taksaon Duangurai, Sarunporn Tandhavanant, Passanesh Sukphopetch, Narisara Chantratita, Nitaya Indrawattana, and Pornpan Pumirat. 2023. "Type VI Secretion System Accessory Protein TagAB-5 Promotes Burkholderia pseudomallei Pathogenicity in Human Microglia" Biomedicines 11, no. 11: 2927. https://doi.org/10.3390/biomedicines11112927
APA StyleLohitthai, S., Rungruengkitkun, A., Jitprasutwit, N., Kong-Ngoen, T., Duangurai, T., Tandhavanant, S., Sukphopetch, P., Chantratita, N., Indrawattana, N., & Pumirat, P. (2023). Type VI Secretion System Accessory Protein TagAB-5 Promotes Burkholderia pseudomallei Pathogenicity in Human Microglia. Biomedicines, 11(11), 2927. https://doi.org/10.3390/biomedicines11112927







